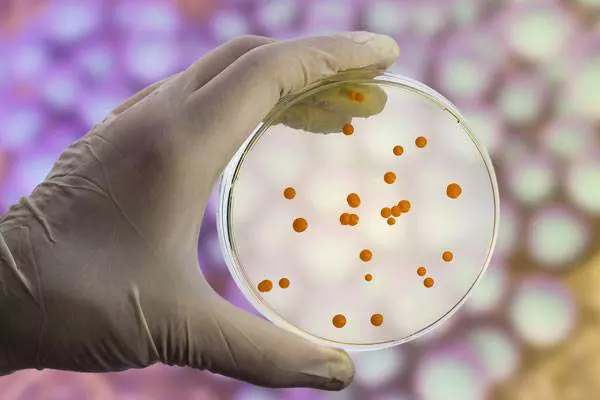
aware project

Celkem padesát čtyři evropských projektů získá podporu Evropské výzkumné rady (ERC) na komerční uplatnění na trhu. V letošní první výzvě Proof of Concept získala nejvíc projektů s velkým odstupem Velká Británie. Projekty z Česka mezi úspěšnými nejsou.
Prestižní granty ERC Proof of Concept jsou určeny na podporu komerčního uplatnění výzkumných projektů, které již dříve obdržely jiný grant od Evropské výzkumné rady. Jen pro rok 2019 je na program vyčleněno na 25 milionů eur.
V prvním letošním kole byla úspěšnost relativně vysoká. Podpořeno bude 54 projektů - soutěže se zúčastnilo 134 projektů. Každý vítězný projekt získá částku 150 000 eur na přípravu byznys plánu, licencování, zajištění ochrany duševního vlastnictví nebo na testování prototypů.
Oněch 54 úspěšných projektů získali vědci z 16 evropských zemích a zemí přidružených k Horizontu 2020. Nejvíc jich obdrží vědci ve Velké Británii (13). Spojené království je v získávání ERC grantů, stejně jako jejich nositelů, tradičně velmi úspěšné. Vědci v Nizozemí získali druhý nejvyšší počet, osm projektů. Švýcarsko dostalo podporu na 5 projektů. Německo a Španělsko získalo po čtyřech projektech. Ze zemí střední a východní Evropy se podporu pro jeden projekt podařilo získat pouze Maďarsku. Češi s žádným projektem neuspěli.
Projekt v Maďarsku získal Csaba Pál z Maďarské akademie věd na komercializaci technologie, která by umožnila připravit takový typ antibiotik, na níž by si bakterie nedokázaly vytvořit rezistenci. Výzkumnice, která získala projekt ve Španelsku, Neus Sabaté, zase bude testovat zařízení na diagnostiku cystické fibrózy z potu. Thomas Elbert z německé Universitat Konstanz bude testovat traumata a psychické zdraví migrantů, kteří přicházejí do Evropy.
Na seznam všech podpořených projektů se můžete podívat zde.
Autor: Vědavýzkum.cz (JT)
Zdroj: Evropská výzkumná rada
- Autor článku: ne
- Zdroj: Vědavýzkum.cz
